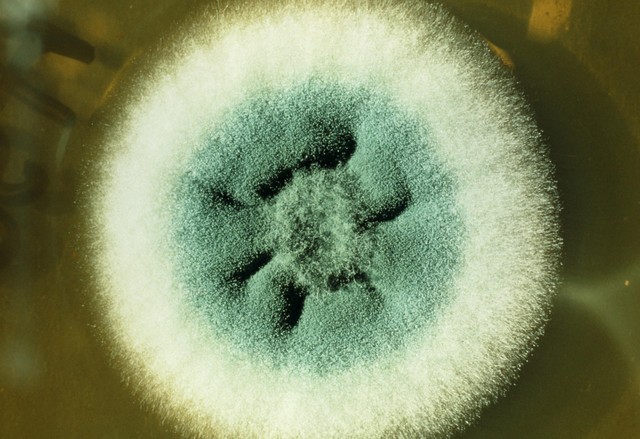

在生物化工的四大系列产品中,有些是用细菌的分泌物做产品;有些是利用菌种繁殖后的躯体做目标产品;也有些是利用细菌分泌的酶,做两种化工原料的催化剂,生成新物质。
现在,化工过来人就带你走进微生物工厂,用你接触过的最熟悉产品,配上最通俗易懂的语言和故事,分别列出生物化工的四大产品工艺及对应的产品。包你看完即懂。
1、代表产品:
替代鱼粉的饲料蛋白。
2、关键特点:
菌体就是最终产品,像“养殖看不见的微生物‘肉’”,常用于饲料或未来食品。
3、核心原理:
微生物“吃”碳源(如甲烷、甲醇)→ 快速繁殖菌体 → 收集干燥成高蛋白产品。
4、大概流程:
我们走进“微生物养猪场”,但“猪”是看不见的甲基营养菌。这些所谓的“猪”是不吃购买的饲料,而是直接往发酵罐里通天然气(主要成分甲烷)当“主食”,再加点氨水当“调味料”,保持38℃温暖环境和充足氧气——这些细菌就会像吹气球一样疯狂繁殖。
3天后,罐子里原本清澈的液体变成乳白色“菌粥”,里面全是细菌的“肉身子”。
把这些菌液送去“脱水车间”,经过离心、干燥,就得到浅黄色粉末,蛋白质含量高达65%~70%(牛肉才20%左右),还富含维生素B12。
养殖户买回去掺在饲料里,鱼、虾、鸡吃了长得飞快。最厉害的是,1000立方米天然气能“养”出1吨这种蛋白,比传统养鱼节省90%的水和土地。
5、简化流程图

6、形象比喻图:
[天然气罐] ➡️ [发酵罐:里面是“甲基营养菌”像小工厂,输入甲烷+氧气,输出“菌团”] ➡️ [离心机:像洗衣机甩干,分离出湿菌体] ➡️ [烘干机:像烤饼干,变成黄色粉末蛋白]
7、现实的工厂:
荷兰某公司建了个年产1.2万吨的“气体蛋白厂”,相当于养活了2.4万头牛的蛋白质产量,却不用占用牧场。
这种工艺的核心是选对“员工”:比如用荚膜甲基球菌当“主力菌”,它吃甲烷的效率特别高,每消耗1摩尔甲烷能长0.45克菌体。现在科学家还在训练“挑食的菌”,让它们直接“吃”工厂废气里的二氧化碳和氢气,真正实现“变废为肉”。
二、酶催化转化(以尼龙原料为例)---像“请微生物当化工厂工人”1、代表产品:
尼龙66关键原料1,6-己二胺。
2、关键特点:
酶是“工具”,不参与最终产品,像“请微生物当化工厂的‘临时工’”。
3、核心原理:
微生物分泌酶 → 酶“剪接”简单分子 → 合成目标材料。
4、大概流程:
我们可以用“生物酶组装乐高积木”来理解化工新材料的酶催化生产——就像用特定工具精准拼接零件,酶能在常温下把简单分子“粘”成高性能材料。最典型的例子是尼龙66关键原料1,6-己二胺的生物合成,这个过程就像用酶当“胶水”,把基础分子一步步粘成工业用的“塑料零件”。
首先,科学家从土壤细菌中找到一种“酰胺水解酶”,它像一把“剪刀”,能把便宜的化工原料己内酰胺(CPL)剪切成6-氨基己酸(ACA)。
但接下来遇到了难题:另一种关键酶“羧酸还原酶”(CAR)对ACA的“粘性”不够,反应速度太慢。研究团队给这种酶做了“基因手术”,通过四个位点突变(L342E/L284T/S986A/D987N),相当于把“胶水配方”改良了,酶活性提升5.3倍。分子动力学模拟显示,改造后的酶结构像更灵活的“手指”,能更好地抓住底物并完成“粘合”动作。
最后一步是搭建“生产线”:把三种功能的工程菌放在同一个发酵罐里,分工合作——第一种负责把CPL剪成ACA,第二种用改良后的CAR把ACA变成6-氨基己醛,第三种再把醛基转化成氨基,最终得到1,6-己二胺。
这个过程比传统化学法优势明显:传统方法要用剧毒的氢氰酸,还需要高温高压,而酶催化就像“室温下拼乐高”,用水做溶剂,副产物只有水和二氧化碳。现在这项技术已经被用来生产生物基尼龙66,未来可能让我们穿的衣服、用的塑料都变成可降解的“绿色材料”。
5、简化流程图

6、形象比喻图:
[原料分子] ➡️ [酶1像剪刀:把分子剪短] ➡️ [酶2像胶水:把“醛基零件”粘上去] ➡️ [酶3像画笔:给分子“画”上氨基] ➡️ [尼龙原料分子:像搭好的乐高积木]
7、现实的工厂:
这条“微型生产线”在100升发酵罐里就能运行,用100 mM CPL原料能产出43.5 mM(代表“毫摩尔每升”(mmol/L))己二胺,产率43.5%,是目前世界最高水平。
三、初级代谢产物(以味精为例):“细菌‘汗滴禾下土’种出的鲜味粉”1、代表产品:
谷氨酸钠(味精)。
2、关键特点:
初级代谢产物(味精生产)。
3、核心原理:微生物“吃饭”时正常代谢 → 分泌初级产物(如氨基酸)→ 提取纯化。
4、大概流程:
这是一家“细菌汗水加工厂”,主角是谷氨酸棒状杆菌,它们的“汗水”就是我们要的鲜味物质。
先给这些细菌准备“营养餐”:玉米淀粉糖化的葡萄糖当“主食”,再加尿素当“氮肥”,硫酸镁、磷酸钾当“矿物质维生素”。把发酵罐调成32℃的“桑拿房”,通入大量氧气,细菌就开始“跑步健身”。
前30小时,细菌忙着“长肌肉”(细胞分裂);
30小时后,关键操作来了:故意“饿”它们一下——断掉生物素(一种维生素),同时把发酵液pH调到7.2。细菌突然“慌了”,细胞膜变得“漏洞百出”,辛辛苦苦合成的谷氨酸就“漏”到培养液里(这一步叫“谷氨酸分泌”)。
50小时后,发酵液里谷氨酸浓度能达到120克/升,相当于每升“细菌汗水”能结晶出120克味精。
最后用“离子交换树脂”当“筛子”,把谷氨酸从复杂的发酵液里“捞”出来,加氢氧化钠中和成谷氨酸钠,再结晶干燥就成了白白的味精。
5、简化流程图:

6、形象比喻图:
[玉米] ➡️ [磨成粉+糖化:变成“葡萄糖粥”] ➡️ [发酵罐:细菌在“粥”里“跑步出汗”,汗就是谷氨酸] ➡️ [加碱:像和面时加小苏打,变成谷氨酸钠] ➡️ [结晶:像冬天窗户结霜,变成味精晶体]
7、现实的工厂:
中国每年用这种方法“种”出200多万吨味精,够全世界人吃一年——你餐桌上的鲜味,可能就来自某罐细菌的“汗水结晶”。
四、次级代谢产物(以青霉素为例):“霉菌‘生病’时熬出的‘抗生素汤药’”1、代表产品:
青霉素(第一种抗生素)。
2、关键特点:
产物是微生物“遇到危险时的防身武器”,像“逼霉菌‘生病’,收集它的‘退烧药’”。
3、核心原理:
微生物“逆境”时启动防御机制 → 合成次级产物(如抗生素)→ 提取入药。
4、大概流程:
这就像开了家“霉菌诊所”,专门等霉菌“生病”时收集它们的“退烧药”。
主角是产黄青霉菌,平时它们吃葡萄糖长得好好的,但我们偏要“折腾”它们:先在“小摇篮”(种子罐)里用营养丰富的培养基让它们“吃饱喝足”,然后突然转移到“粗粮罐”——减少葡萄糖,增加乳糖和玉米浆,同时把温度从25℃降到20℃。
环境一变,青霉菌“吓坏了”,以为遇到危险,赶紧启动“防御系统”——合成青霉素这种“化学武器”来杀死周围的竞争对手。这时候发酵罐里会出现白色的“霉菌棉花球”,抗生素就藏在这些“棉花”和培养液里。发酵7天后,往罐子里加醋酸丁酯当“萃取剂”,就像用吸管把“汤药”里的有效成分“吸”出来,再提纯结晶,得到白色的青霉素粉末。
最神奇的是“前体喂养”技巧:在发酵后期加苯乙酸,青霉菌会“顺手”把它接到青霉素分子上,让药效更强(这就是青霉素G的来源)。
5、简化流程图:

6、形象比喻图:
[青霉菌“种子”] ➡️ [小发酵罐:让霉菌“住单间”长壮] ➡️ [大发酵罐:突然断“高级营养”,霉菌“紧张”开始产青霉素自卫] ➡️ [萃取:像用吸管从汤里吸出油花,吸出青霉素] ➡️ [结晶:变成白色粉末,做成抗生素]
7、现实的工厂:
二战时科学家用这种方法,把青霉素产量从每毫升2单位提高到200单位,救了上千万士兵的命——现在医院里的头孢、阿莫西林,都是用类似“逼霉菌生病”的方法“熬”出来的。
五、总结:四种“微生物工厂”的核心区别这些看不见的“微生物打工人”,正用它们的身体、汗水、分泌物,甚至“防御武器”,为我们生产从饲料到药品的各种材料。
这些流程图就像微生物的“工作说明书”:有的微生物负责“长身体”,有的当“工具人”,有的“日常流汗”,有的“应急产药”。
本质上都是人类“雇佣”微生物,用它们的生命活动实现工业化生产——这就是生物化工的“微观智慧”。

未来随着基因编辑技术发展,我们还能让它们“跨界打工”——比如让酵母既“长肉”又“产抗生素”,或者让大肠杆菌“吐出”可降解塑料。大自然藏在微观世界的“生产线”,远比我们想象的更万能。
如果需要更具体的某一步图解(如发酵罐结构、酶分子作用示意图),可以进一步说明!